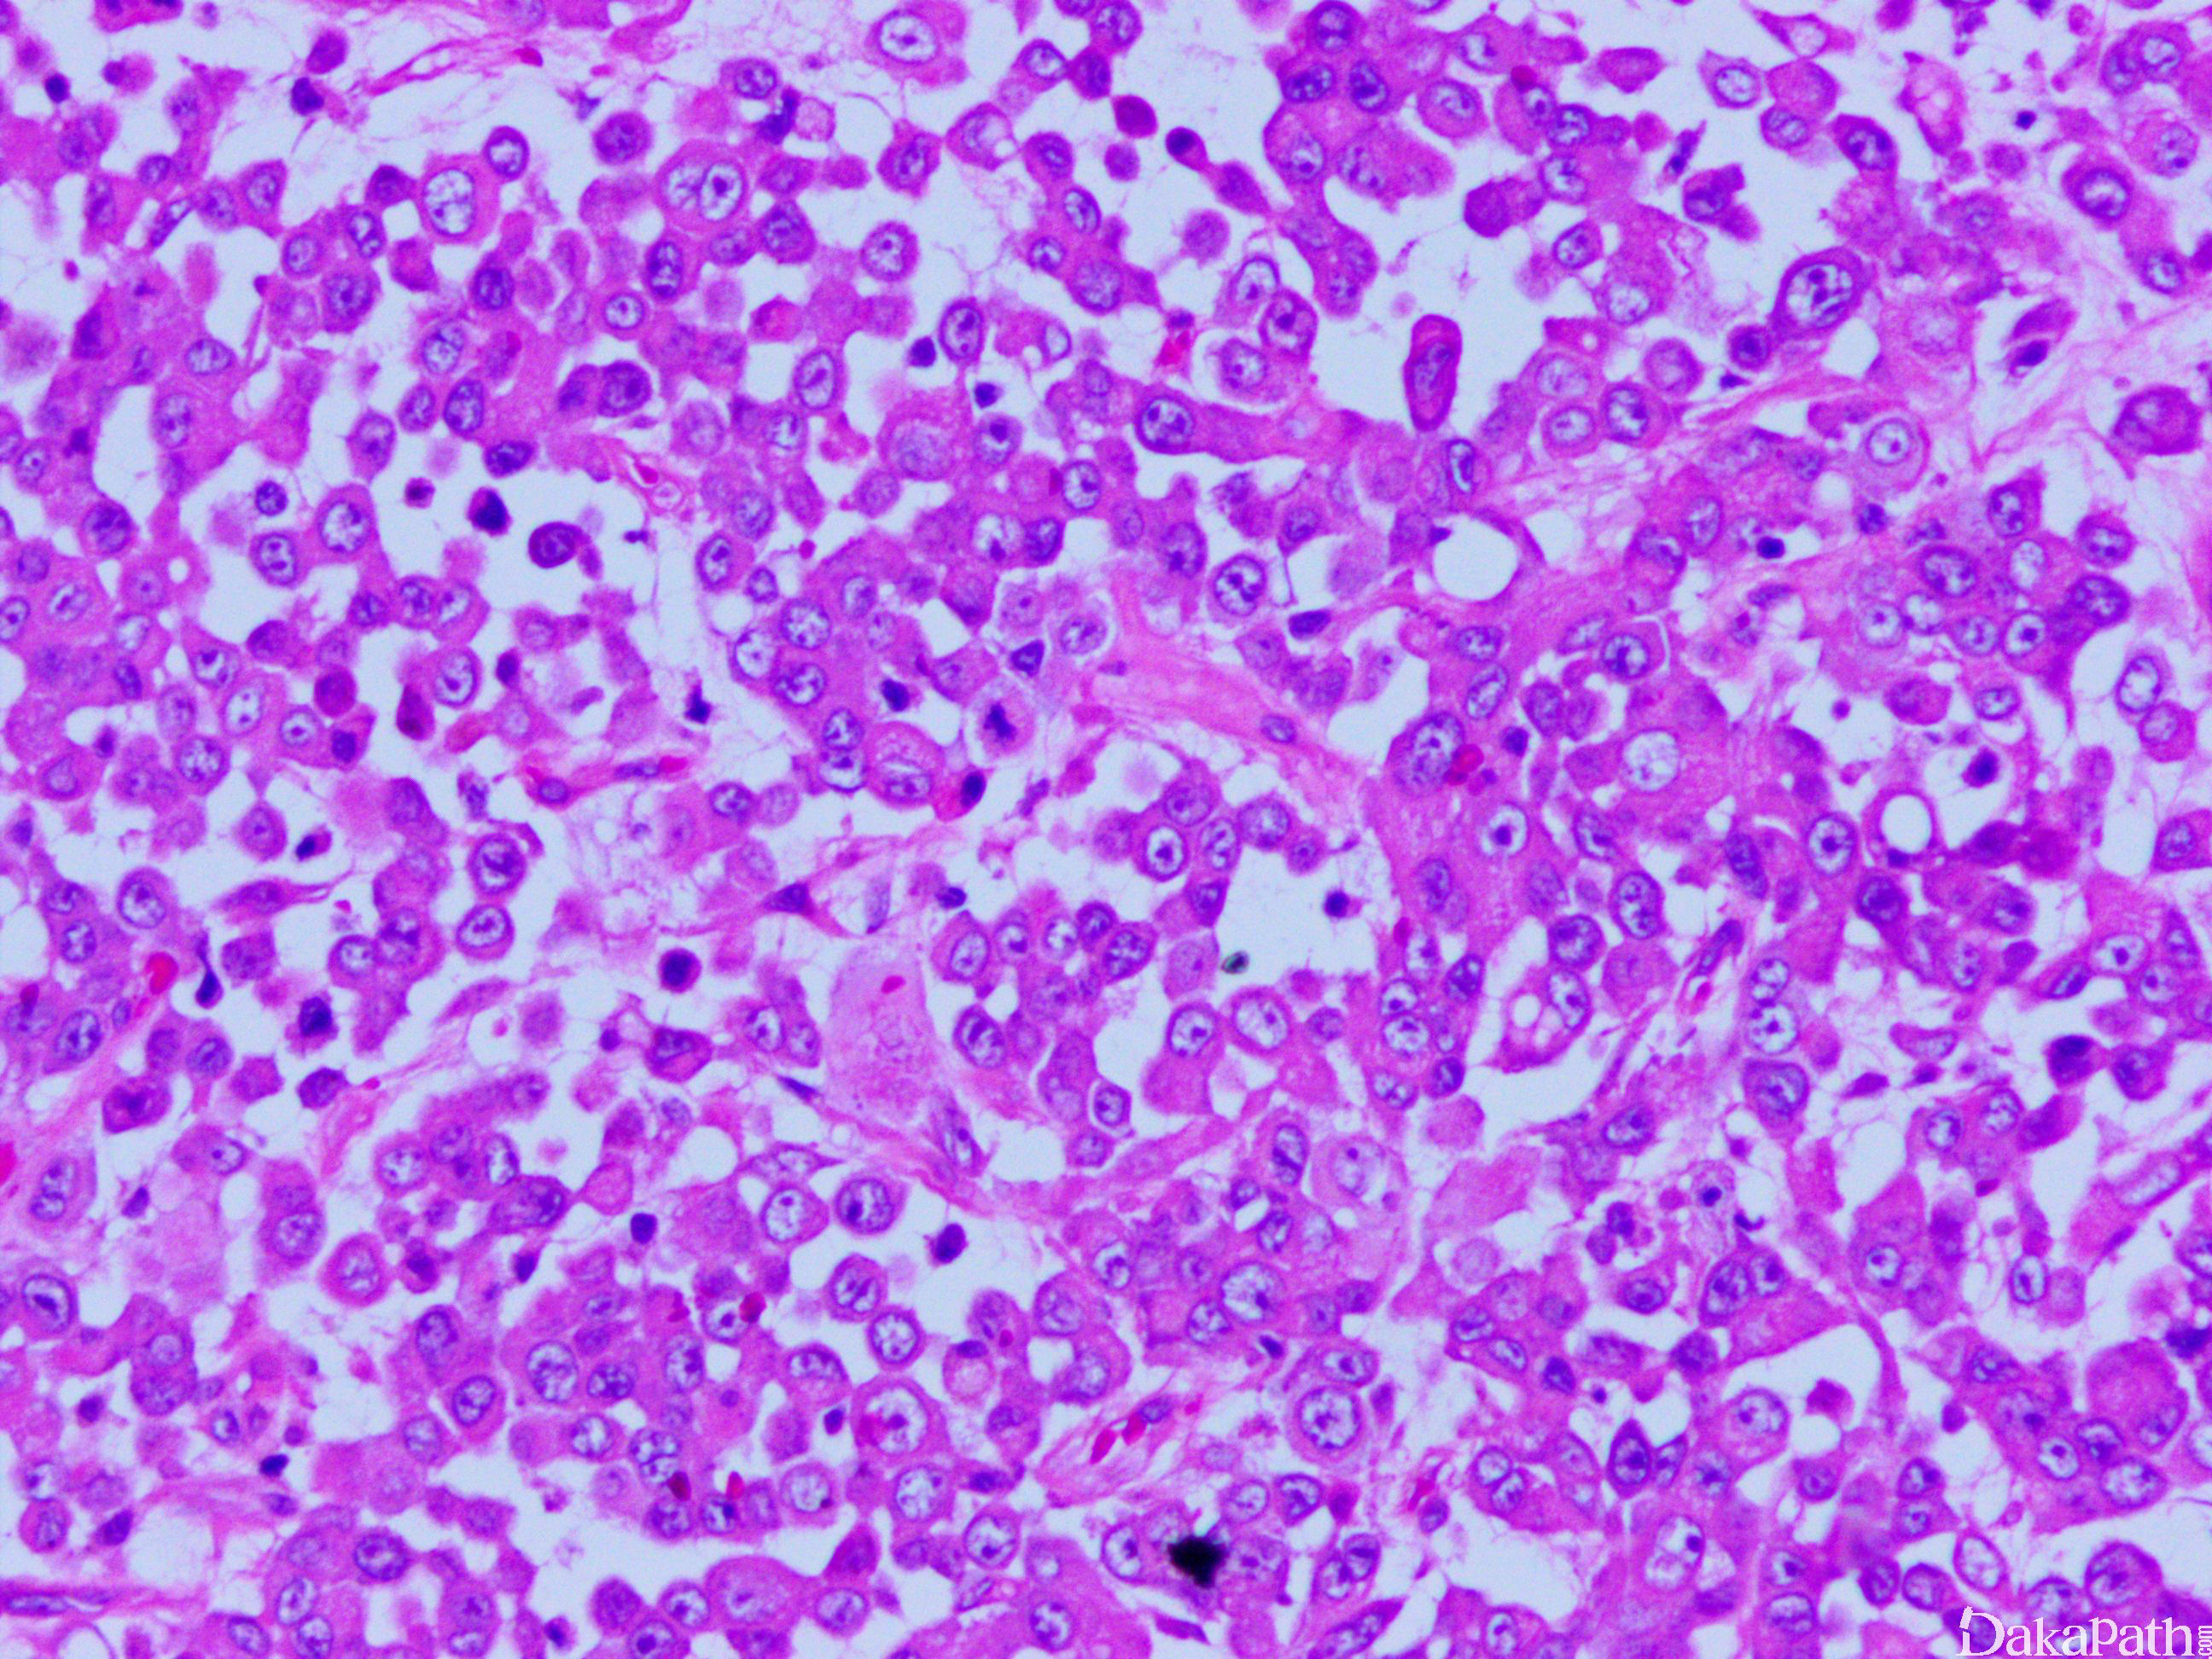

肾脏横纹肌样瘤
Rhabdoid Tumour of Kidney
概述:
是发生于低龄儿童的具有高度侵袭性和致命性的肿瘤,肿瘤细胞有囊泡状染色质,核仁突出,细胞浆内有玻璃样变的包涵体。
发病部位: 肾脏
诊断要点:
- 约占所有儿童肾脏肿瘤的 2%,诊断时平均年龄约 1 岁, 3 岁以上患病非常少见;
- 肿瘤较大,边界不清,无包膜,伴有出血和坏死,提示具有高度侵袭性。
- 镜下见成片的形态相对一致的恶性圆形细胞浸润至周围肾实质,常有广泛血管浸润;
- 肿瘤细胞有三个特点:囊泡状染色质,显著的红核仁和粉染玻璃样浆内包涵体,这些细胞在不同病例及同一病例不同视野多少不等;
- 部分病例可能主要由原始未分化小圆形细胞构成,但是仔细寻找可见灶状分布的诊断性横纹肌样细胞。

免疫组织化学染色:
Vimentin 及 CK 可突出显示胞浆玻璃样包涵体;SMARCB1(INI 1)丢失对该肿瘤的诊断具有较高的特异性及敏感性。
分子标记:
SMARCB1 缺失
鉴别诊断:
小圆细胞未分化肉瘤:部分肾脏横纹肌样瘤可能主要由原始未分化小圆形细胞构成,但是仔细寻找可见灶状分布的诊断性横纹肌样细胞。免疫组化染色 INI1 表达缺失可帮助确诊。
伴有横纹肌样特征的尿路上皮癌或肾细胞癌:基本发生于成人,通常可见典型的低级别肾细胞癌成分,免疫组化染色表达 PAX8,CD10 等。
预后:
预后差,80%以上患者在诊断后 2 年之内死亡
治疗:
手术+化疗
病例报道:
Rhabdoidtumour of kidney. Acasereport.
参考文献:
Hollmann TJ, Hornick JL. INI1-deficient tumors: diagnostic features and molecular genetics. Am J Surg Pathol 2011;35:e47-63.
